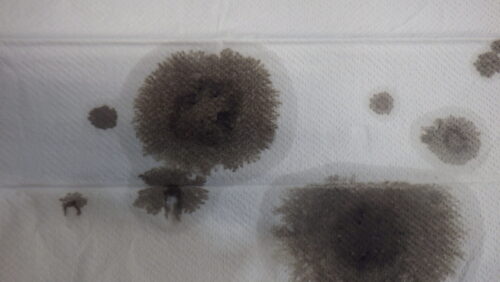

- 車
2025.12.19
今年の汚れは今年のうちに
WPC処理が終わったクランクシャフト
いつも通り完璧な仕上がり
しかしここからが大変…
set完了!下には新品のペーパーウエス
では!!
もういっちょ!
ほいっ!!
そう、OILラインの止まり部分の
OIL残りと蓄積されたスラッジ
うえぇ~
まあ使用済(現車外し)のクランク
なんてこんな感じですよ
4気筒の場合、この止まり部4か所を
繰り返しきれいになるまで洗浄
洗浄液にOILやスラッジがないでしょ?
ここまで仕上げで洗浄して、さらにスコープ
で目視確認して終了です
WPC処理に出すと強化、摺動性向上、
プーリー軸カジリ抑制をやってさらに
徹底洗浄がもれなくついてきます
これは別のクランク…
これも酷かった
WPC処理するしないは別に
バラしたクランクは必ず洗浄しましょう!
今年の汚れは今年のうちに!